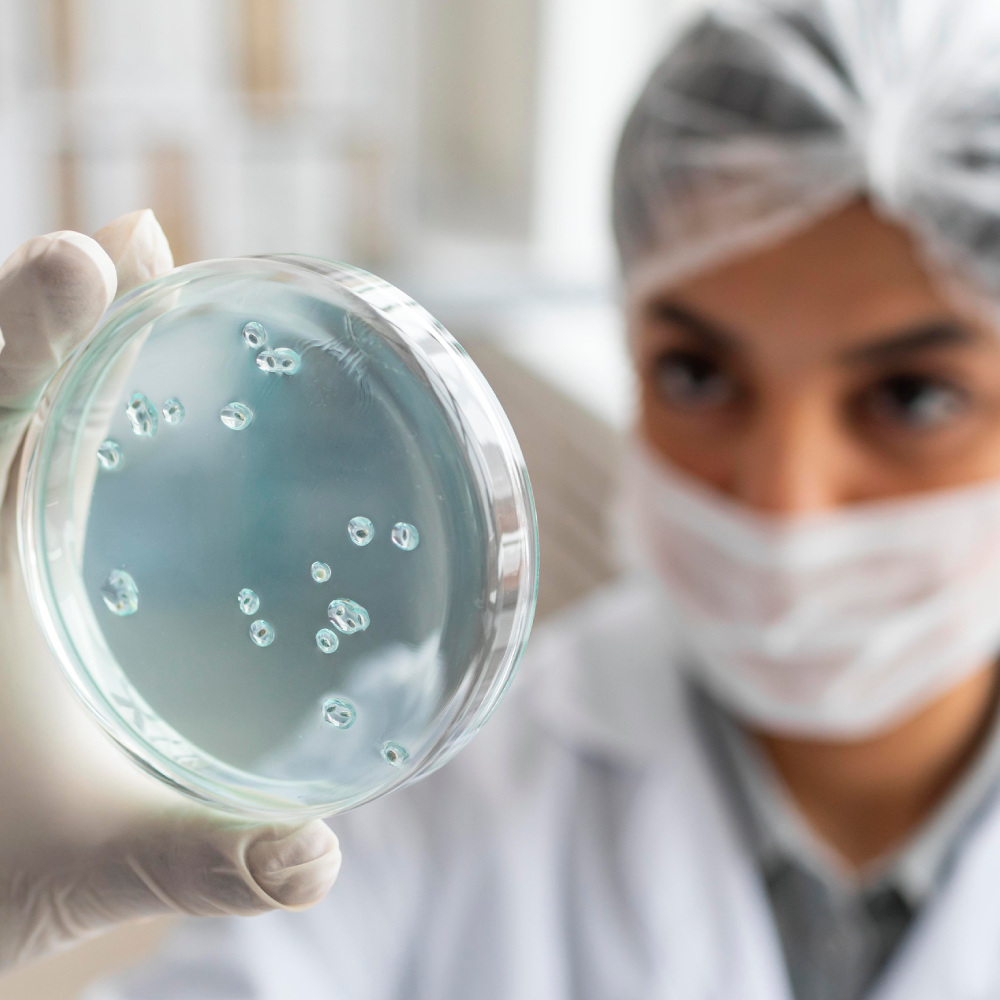
Mikroorganismen

Mikroorganismen
Professionelle Luftreinigung gegen Viren, Bakterien und Pilze für gesunde Raumluft
Pilze, Viren und Bakterien sind so gut wie immer vorhanden, sei es durch Außenluftquellen oder Innenraumquellen, wie Pflanzen, Aquarien, Haustiere etc. – auch wenn man keinen Schimmelpilzschaden in den eigenen Räumen hat.
Diese Mikroorganismen können nicht nur allergische Reaktionen auslösen, sondern auch Infektionen verursachen und das Immunsystem belasten. Besonders in geschlossenen Räumen können sich Viren und Bakterien schnell verbreiten.
Mit professionellen Luftreinigern können Sie die Konzentration von Mikroorganismen in der Raumluft deutlich reduzieren und so ein gesünderes Raumklima schaffen.
Häufige Mikroorganismen in der Raumluft
Viren
Luftübertragene Viren wie Grippe- oder Erkältungsviren können durch Aerosole in der Raumluft übertragen werden.
Bakterien
Bakterien in der Luft können Infektionen verursachen und sind besonders in schlecht belüfteten Räumen problematisch.
Pilzsporen
Schimmelpilzsporen sind fast überall vorhanden und können bei erhöhter Konzentration gesundheitliche Beschwerden verursachen.
Schutz durch HyperHEPA-Filtertechnologie
Die HyperHEPA-Filter von IQAir filtern nicht nur Partikel, sondern auch die kleinsten Mikroorganismen wie Viren und Bakterien aus der Raumluft. Die Filterung erfolgt rein mechanisch – ohne den Einsatz von chemischen Zusätzen oder UV-Licht.
- Filtert bis zu 99,5% aller luftübertragenen Viren und Bakterien
- Entfernt Schimmelpilzsporen und deren Stoffwechselprodukte
- Rein mechanische Filterung – keine chemischen Zusätze
- Besonders wichtig in Kitas, Schulen und Büros
Empfohlene Luftreiniger gegen Mikroorganismen
Diese IQAir Luftreiniger sind besonders effektiv bei der Filterung von Viren, Bakterien und Pilzsporen aus der Raumluft.

IQAir GC MultiGas
Spezialluftreiniger für Gas- und Geruchsfilterung
- Gas- und Geruchsfilterung
- Chemische Filtration

IQAir HealthPro 100
Kompakter Luftreiniger mit höchsten Wirkungsgraden
- Höchster Wirkungsgrad
- Lange Filterstandzeit

IQAir HealthPro 150
Mittelgroßer Luftreiniger für optimale Raumluft
- Höchster Wirkungsgrad
- Lange Filterstandzeit

IQAir HealthPro 250
Premium Luftreiniger für höchste Ansprüche
- Höchster Wirkungsgrad
- Lange Filterstandzeit
Beratung gewünscht?
Unsere Experten helfen Ihnen gerne bei der Auswahl des optimalen Luftreinigers für gesunde und keimfreie Raumluft.